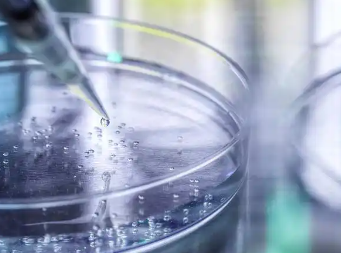
image.png

干細(xì)胞存儲(chǔ)多少錢,有哪些存儲(chǔ)方案可選
2024-11-26 15:41:04 來源: 小編 咨詢醫(yī)生
干細(xì)胞存儲(chǔ)作為一項(xiàng)前沿的生物技術(shù),受到越來越多家庭的關(guān)注。那么,干細(xì)胞存儲(chǔ)到底需要多少錢?有哪些存儲(chǔ)方案可選?本文將為您詳細(xì)解析干細(xì)胞存儲(chǔ)的相關(guān)問題。
一、干細(xì)胞存儲(chǔ)的費(fèi)用
干細(xì)胞存儲(chǔ)的費(fèi)用因存儲(chǔ)機(jī)構(gòu)、存儲(chǔ)方式、存儲(chǔ)時(shí)間等因素而有所不同。一般來說,干細(xì)胞存儲(chǔ)的費(fèi)用包括以下幾個(gè)部分:
1.初始采集費(fèi)用:干細(xì)胞采集需要專業(yè)的設(shè)備和人員,費(fèi)用通常在幾千到幾萬元不等。
2.存儲(chǔ)費(fèi)用:存儲(chǔ)費(fèi)用主要包括干細(xì)胞凍存、實(shí)驗(yàn)室管理、設(shè)備維護(hù)等,費(fèi)用通常為每年幾千元。
3.管理費(fèi)用:為了確保干細(xì)胞的安全存儲(chǔ),存儲(chǔ)機(jī)構(gòu)會(huì)收取一定的管理費(fèi)用,費(fèi)用約為每年幾百元。
綜上所述,干細(xì)胞存儲(chǔ)的總費(fèi)用大約在每年幾千到幾萬元之間,具體費(fèi)用還需根據(jù)實(shí)際情況咨詢相關(guān)機(jī)構(gòu)。
二、干細(xì)胞存儲(chǔ)方案
以下是幾種常見的干細(xì)胞存儲(chǔ)方案:
1.自體存儲(chǔ)
自體存儲(chǔ)是指將本人或家庭成員的干細(xì)胞存儲(chǔ)起來,以備不時(shí)之需。這種方案適用于有家族遺傳病史、疾病風(fēng)險(xiǎn)較高的人群。自體存儲(chǔ)的優(yōu)勢(shì)在于,干細(xì)胞來源可靠,避免了免疫排斥的風(fēng)險(xiǎn)。
2.同胞間存儲(chǔ)
同胞間存儲(chǔ)是指將兄弟姐妹的干細(xì)胞存儲(chǔ)起來,用于相互救助。這種方案適用于有兩個(gè)或多個(gè)孩子家庭。同胞間存儲(chǔ)的優(yōu)勢(shì)在于,干細(xì)胞來源相對(duì)可靠,且免疫排斥風(fēng)險(xiǎn)較低。
3.公共庫存儲(chǔ)
公共庫存儲(chǔ)是指將無人認(rèn)領(lǐng)的干細(xì)胞捐贈(zèng)給公共干細(xì)胞庫,供有需要的人使用。這種方案適用于無私奉獻(xiàn)、愿意幫助他人的家庭。公共庫存儲(chǔ)的優(yōu)勢(shì)在于,可以為他人提供生的希望,且無需承擔(dān)存儲(chǔ)費(fèi)用。
4.家庭庫存儲(chǔ)
家庭庫存儲(chǔ)是指將家庭成員的干細(xì)胞存儲(chǔ)在私人干細(xì)胞庫中,以備家庭內(nèi)部使用。這種方案適用于有家族遺傳病史、疾病風(fēng)險(xiǎn)較高的家庭。家庭庫存儲(chǔ)的優(yōu)勢(shì)在于,干細(xì)胞來源可靠,且免疫排斥風(fēng)險(xiǎn)較低。
三、總結(jié)
干細(xì)胞存儲(chǔ)作為一項(xiàng)寶貴的生物資源,具有廣泛的應(yīng)用前景。在選擇干細(xì)胞存儲(chǔ)方案時(shí),家庭需根據(jù)實(shí)際情況和經(jīng)濟(jì)條件進(jìn)行權(quán)衡。同時(shí),建議選擇專業(yè)、正規(guī)的干細(xì)胞存儲(chǔ)機(jī)構(gòu),確保干細(xì)胞的安全存儲(chǔ)。隨著干細(xì)胞技術(shù)的不斷發(fā)展,未來干細(xì)胞存儲(chǔ)將為更多家庭帶來健康保障。
- 2024-10-24安徽高效干細(xì)胞價(jià)格如何?性價(jià)比高嗎?
- 2024-09-24廈門干細(xì)胞豐胸費(fèi)用大概多少錢一次
- 2025-08-13三明醫(yī)院可以打免疫細(xì)胞嗎費(fèi)用多少
- 2024-10-10植物干細(xì)胞再生療法價(jià)格多少?效果對(duì)比分析
- 2024-11-27干細(xì)胞治療血栓費(fèi)用多少,治療效果好嗎
- 2024-07-27打干細(xì)胞多少錢一針,打干細(xì)胞有風(fēng)險(xiǎn)嗎
- 2024-09-04干細(xì)胞存儲(chǔ)機(jī)構(gòu)資質(zhì)要求,經(jīng)營干細(xì)胞項(xiàng)目需要什么資質(zhì)
- 2024-10-08鹽城牙髓干細(xì)胞存儲(chǔ)流程復(fù)雜嗎?需要注意什么?
- 2024-09-07干細(xì)胞技術(shù)的講解,一文讀懂什么是干細(xì)胞
- 2024-09-04干細(xì)胞抗衰老有效果嗎,有副作用嗎
- 2024-08-29肝硬化干細(xì)胞療法效果,干細(xì)胞移植肝硬化利弊
- 2024-07-29存儲(chǔ)臍帶質(zhì)干細(xì)胞,存儲(chǔ)臍帶質(zhì)干細(xì)胞的作用
- 2024-09-24合肥肝硬化干細(xì)胞功效,干細(xì)胞能治療肝硬化嗎
- 2024-09-15長(zhǎng)春干細(xì)胞醫(yī)院哪家好,上榜前十名單公布
- 2024-08-15腸癌干細(xì)胞療法能治愈嗎
- 2024-08-21脂溢性脫發(fā)干細(xì)胞療法,解決脫發(fā)問題的新希望
- 2024-10-07嘉興肝硬化干細(xì)胞功效如何,能否有效改善病情
- 2024-09-16白血病干細(xì)胞移植費(fèi)用多少錢,醫(yī)保能報(bào)銷嗎
